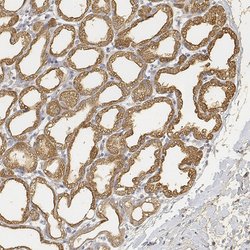
Invitrogen LALBA Polyclonal Antibody 100 &mu;L | Buy Online | Invitrogen&trade; | Fisher Scientific

missing translation for 'onlineSavingsMsg'
Learn More
Learn More
Description
Immunogen sequence: QVPQSRNICD ISCDKFLDDD ITDDIMCAKK ILDIKGIDYW LAHKALCTEK LEQWLCEK Highest antigen sequence identity to the following orthologs: Mouse - 71%, Rat - 74%.
This gene encodes alpha-lactalbumin, a principal protein of milk. Alpha-lactalbumin forms the regulatory subunit of the lactose synthase (LS) heterodimer and beta 1,4-galactosyltransferase (beta4Gal-T1) forms the catalytic component. Together, these proteins enable LS to produce lactose by transfering galactose moieties to glucose. As a monomer, alpha-lactalbumin strongly binds calcium and zinc ions and may possess bactericidal or antitumor activity. A folding variant of alpha-lactalbumin, called HAMLET, likely induces apoptosis in tumor and immature cells.

Specifications
Specifications
| Antigen | LALBA |
| Applications | Immunohistochemistry (Paraffin), Western Blot |
| Classification | Polyclonal |
| Concentration | 0.10 mg/mL |
| Conjugate | Unconjugated |
| Formulation | PBS with 40% glycerol and 0.02% sodium azide; pH 7.2 |
| Gene | LALBA |
| Gene Accession No. | P00709 |
| Gene Alias | ALACTA; a-LACTA; alfaLA; alpha lactabumin; alpha lactalbumin; alpha-lactalbumin; alpha-lactalbumin A; alpha-lactalbumin B; alpha-lactalbumin precursor (EC 2.4.1.22); alpha-lactalbumin precursor protein; alpha-lactalbumin protein variant D; Bos d 4; lactalbumin; lactalbumin alpha; lactalbumin, alpha; lactalbumin, alpha-; lactalbumin, alpha- precursor; lactose synthase B protein; Lalba; lysozyme G; lysozyme-like protein 7; LYZG; LYZL7; MGC138521; MGC138523 |
| Gene Symbols | LALBA |
| Show More |
Product Title
By clicking Submit, you acknowledge that you may be contacted by Fisher Scientific in regards to the feedback you have provided in this form. We will not share your information for any other purposes. All contact information provided shall also be maintained in accordance with our Privacy Policy.
Spot an opportunity for improvement?